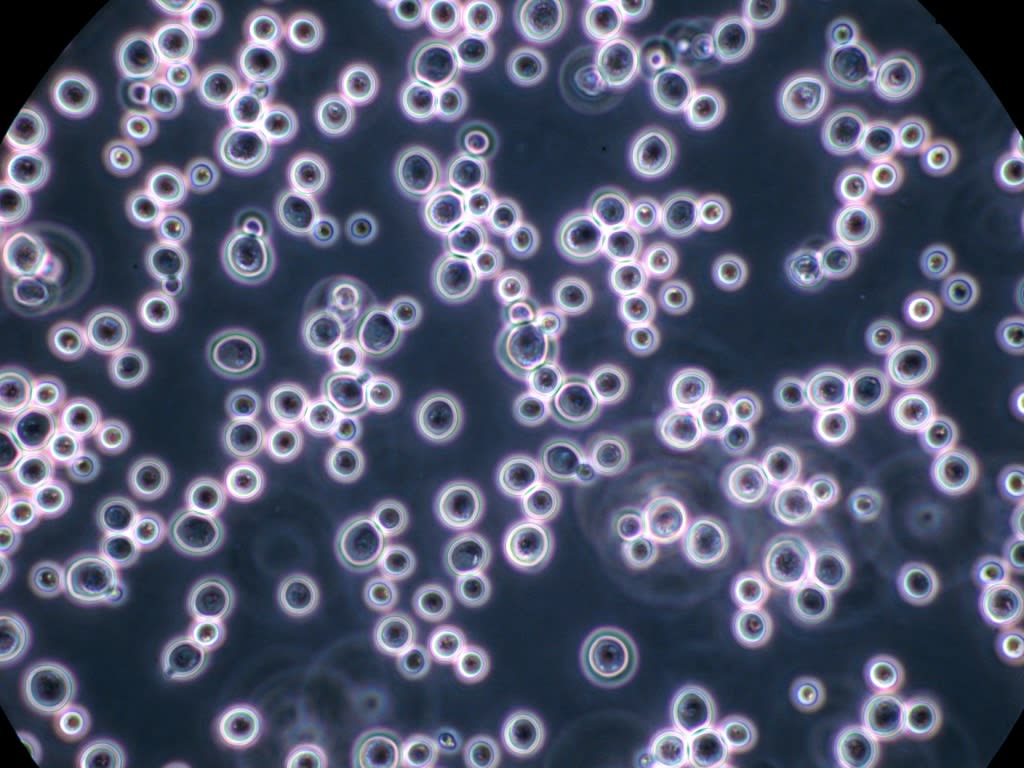

BEERSELECTION
FEATURED YEASTS
 Filter
Filter
FERMOLAGER Munich Heritage
Sales tax exclusive
FERMOALE WEISS
Sales tax exclusive
FERMOLAGER Crisp
Sales tax exclusive
FERMOALE German K
Sales tax exclusive
FERMOALE NEW-E
Sales tax exclusive
FERMOALE AY4
Sales tax exclusive
FERMOLAGER W
Sales tax exclusive
FERMO Kveik SV
Sales tax exclusive
FERMOALE AY3
Sales tax exclusive
FERMOLAGER Berlin
Sales tax exclusive
FERMOALE
Sales tax exclusive
FERMOALE Bel-Abbey
Sales tax exclusive
FERMO Brew Acid
Sales tax exclusive


 Argentina
Argentina
 Australia
Australia
 Brazil
Brazil
 Chile
Chile
 China
China
 Germany
Germany
 Hungary
Hungary
 Italy
Italy
 South Africa
South Africa